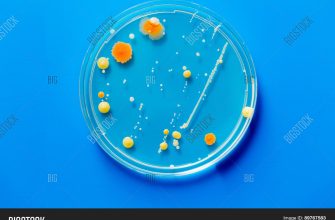

Согласно планам NASA, в 2020 году на окололунной орбите должна быть развернута система, которая сможет самостоятельно выводить в открытый космос пилотируемые корабли. В 2023 году на единственный спутник Земли отправится первая за почти полвека пилотируемая миссия. Освоение Луны позволит создать стартовую площадку для последующей высадки человека на Марс (запланирована на 2030-е годы). Поэтому, помимо создания новой космической техники, NASA в течение многих лет исследует технологии добычи и переработки внеземных природных ресурсов и производства из них необходимых космонавтам вещей.
Спиночесалка из принтера
В сентябре 2014 года на Международную космическую станцию (МКС) была доставлена установка объемной печати компании Made In Space, на которой спустя 2,5 месяца (именно столько времени заняла пусконаладка) напечатали первую пригодную к использованию пластмассовую деталь – лицевую защитную панель печатающей головки. В общей сложности в ходе испытаний инновационного принтера в условиях нулевой гравитации были изготовлены более 20 предметов, в том числе такая полезная в космическом хозяйстве вещь, как спиночесалка.
Астронавт Сэм Кристофоретти на МКС проводит тестовые испытания 3D-принтера на орбите
Электронные коды деталей передавались с Земли на орбиту по e-mail. По возвращении все напечатанные предметы были протестированы на сжатие, скручивание, изгиб и вытягивание, а также изучены под микроскопом. Космические детали также сравнивали с аналогами, изготовленными в земных условиях. Существенных отклонений в химическом составе и прочностных свойствах выявлено не было, но влияние невесомости все же проявилось во внутренней структуре материала.
Идея использовать трехмерные принтеры в космосе лежала практически на поверхности: доставка грузов на орбиту по-прежнему стоит тысячи долларов США за килограмм. При таких расходах создание базовой колонии на Луне, а тем более на Марсе, не под силу ни одной из стран, поэтому Made In Space получила заказ NASA на разработку космического принтера еще в 2010 году. Компания смогла решить проблему улавливания газов, выделяемых при спекании полимера, обеспечила возможность удаленного управления установкой и, наконец, поместила интеллектуальную начинку в устойчивый к повреждениям корпус.
В качестве расходного материала для объемной печати в космосе инженеры NASA после длительных исследований выбрали акрилонитрилбутадиенстироловый пруток. Первоначально экспериментировали с парафинами и нейлоном, однако эти материалы не подошли по удельной массе и температуре экструзии. Подача сырья в виде прутка стала базовым вариантом, поскольку порошок в условиях невесомости неконтролируемо разлетается, а жидкие смолы вместо необходимого по технологии кубического сечения приобретают круглое.
Марсианский бетон
После успешных тестов первой установки NASA усложнила условия, поставив Made In Space задачу сконструировать полностью автономную систему печати и сборки крупных объектов в космосе. А некоторое время спустя, в мае 2015 года, был объявлен конкурс с призовым фондом 2,25 млн долл. на проектирование жилых модулей для поселений на других планетах. Соревнование было разделено на четыре этапа: на первом участники должны были представить архитектурные проекты, на втором – технологию производства строительных материалов, на третьем – продемонстрировать возможности автономной сборки жилых модулей.
На орбите на 3D-принтере напечатано уже несколько десятков различных деталей
На первом этапе NASA получила 165 вариантов дизайна, из которых отобрали 30 наиболее перспективных. Основным критерием для оценки была возможность постройки спроектированного здания средствами объемной печати на основе имеющихся на Марсе ресурсов. Также жюри приняло во внимание архитектурные достоинства, комфортность, инновационность и функциональность объектов. Первое место и приз 25 тыс. долл. за Mars Ice House получил консорциум Space Exploration Architecture и Clouds Architecture Office. Воображение большинства конкурсантов рисовало надувные купола, присыпанные грунтом, с темными и неуютными помещениями, создающими угрозу психологическому комфорту команды. В противоположность Mars Ice House высоко возвышается над поверхностью планеты полупрозрачным плавником из этилен-тетрафторэтиленовой пленки.
Второй этап конкурса NASA проходил в 2017 году и был посвящен поискам наиболее эффективного строительного материала. Участники должны были за определенный отрезок времени напечатать три балки и три цилиндра из полимера и имитации марсианского грунта, так называемого реголита. Изделия затем были подвергнуты прочностным тестам. Главный приз 250 тыс. долл. достался команде The Foster + Partners и Branch Technology, опередившей около 80 конкурентов. Чемпионская технология использует всего 30% полимера, который космонавтам-колонистам, скорее всего, предстоит привезти с Земли. Теоретическая возможность изготавливать полимеры прямо на Марсе, улавливая двуокись углерода из воздуха и выделяя водород из имеющихся на планете запасов воды, существует. Однако достоверных свидетельств наличия на Марсе достаточных запасов жидкости по-прежнему нет.
Площадка, где конкурсанты показывали экспертам NASA прототипы своих разработок
Большинство зданий на нашей планете построены из бетона. Инженеры NASA полагают, что марсианский грунт сможет заменить его. Данные, полученные со спускаемых аппаратов, свидетельствуют, что в составе грунта Красной планеты превалируют диоксид кремния и окись железа, есть достаточная доля оксидов алюминия, кальция и серы. К сожалению, ни одной крупинки марсианского грунта на Земле до сих пор нет, поэтому NASA работает с его имитациями, изготовленными из продуктов вулканических извержений.
Основой традиционного бетона является цемент, получаемый из смеси известняка и воды. Земной известняк преимущественно образован останками морских животных, которых на Марсе никогда не было. Однако ученые смогли получить прочный цемент, смешав имитацию реголита с серой. Но в реальной жизни использовать этот материал невозможно. Во-первых, неармированный бетон крайне хрупок. Но из чего можно сделать арматуру на далекой планете, пока непонятно. Во-вторых, сера имеет низкую термостойкость, поэтому, если в доме из такого цемента вдруг возникнет пожар, стены буквально расплавятся. В-третьих, сера имеет характерный неприятный запах, жить с которым очень некомфортно.
Проблемы с запахом и термостойкостью можно устранить, если покрыть марсианский бетон слоем полимера, например полиэтиленом высокой плотности. При этом полимерное покрытие марсианских зданий будет выполнять еще одну важную функцию – защищать людей от воздействия радиации. Компания International Scientific Technologies уже смогла получить строительные блоки из реголита и модифицированных полимеров, эффективно блокирующих космическую радиацию и солнечные частицы. Параллельно в NASA изучают возможности использования биопластиков. Они пригодятся для изготовления не только жилых модулей, но и медицинских инструментов и космических теплиц.
Массовая застройка
Сегодня в самом разгаре третья фаза конкурса NASA, которую разделили на пять стадий. Сначала соревновались компании, специализирующиеся на компьютерном моделировании. Спроектированные здания должны были иметь жилую площадь порядка 90 кв. м и системы жизнеобеспечения, способные поддерживать существование четырех астронавтов на протяжении целого года. Лучшим признали проект Zopherus, главным достоинством которого является наличие передвижной строительной установки. Перемещаясь по поверхности, этот марсоход собирает лед, оксид кальция и камни, из которых замешивается бетон. Затем запускается принтер и печатает секции жилых модулей.
Параллельно с компьютерным моделированием началась строительная стадия третьей фазы, в которой участники должны были предложить наилучший материал для фундамента марсианских зданий. Как и в первой фазе, здесь выиграла Space Exploration Architecture. На этот раз ей помогала фирма Apis Cor – первый в мире разработчик трехмерных принтеров, способных работать непосредственно на строительной площадке. В оставшихся испытаниях командам предстоит напечатать весь объем фундамента и цилиндрическую стену с отверстиями, которые подвергнут гидростатическим тестам. Затем будет изготовлена натурная модель здания в масштабе 1:3. После этого будет определен абсолютный победитель третьей фазы.
До момента, когда мечты о покорении далеких планет воплотятся в реальность, осталось не так много времени. Например, Илон Маск надеется отправить первого человека на Марс уже через шесть лет. По его задумке колонисты будут жить в тоннелях, вырытых специальной техникой: как отмечалось выше, в безопасных, но далеко не самых комфортных условиях. Тщательная многолетняя подготовка NASA, напротив, позволит космическим колонистам избежать многих трудностей и проблем. А с настоящей победой ученых и инженеров можно будет поздравить, когда инновационные разработки для безопасного покорения Луны и Марса найдут применение в повседневной земной жизни.
Взгляд со стороны
Константин Михайловский,
начальник отдела разработки и изготовления деталей из полимерных композиционных материалов компании «Композит» (входит в госкорпорацию «Роскосмос»):
Классический метод строительства марсианских баз заключался в том, чтобы создавать все объекты заранее на Земле, а затем уже в собранном виде доставлять их на Красную планету. Однако затем от реализации этой концепции было решено отказаться, поскольку она потребовала бы выводить в космос очень тяжелые и габаритные конструкции.
Ей на смену пришла идея отправить на поверхность Марса оборудование для 3D-печати конструкций с использованием местного сырья. Преимуществом этого метода является то, что с его помощью можно создавать достаточно крупные объекты, которые не потребуют большого количества строительных материалов, привезенных с Земли.
Однако имеются у 3D-печати и свои недостатки. В частности, для создания такого производства необходима мощная система генерации электроэнергии. Связано это с тем, что в марсианском грунте присутствует большое количество оксида железа, обработка которого требует больших энергозатрат. Поэтому, перед тем как начинать возводить марсианскую базу с помощью аддитивных технологий, мы должны будем доставить и смонтировать на «стройплощадке» большое количество солнечных панелей и аккумуляторных батарей.
Mars Ice House возвышается над поверхностью планеты полупрозрачным плавником из этилен-тетрафторэтиленовой пленки
Нужно сказать, что интересной альтернативой использованию 3D-принтера сейчас является строительство марсианской базы с помощью так называемых надувных конструкций, которые очень компактны в сложенном виде и значительно увеличивают свои размеры во время развертывания. В частности, к отсекам данного типа относится модуль BEAM, который в 2016 году был пристыкован к МКС для испытаний и в настоящее время исследуется специалистами.
В надувных конструкциях в качестве одной из оболочек применяются термопластичные полиэфирные полимеры (в частности, полиэфиркетоны), которые позволяют обеспечить изделию очень хорошую герметичность при высокой эластичности, необходимой для успешного развертывания. Причем свои свойства данный материал сохраняет даже при экстремальном холоде (–100 °С и ниже).
Среди основных требований к зданиям обитаемой марсианской базы в первую очередь стоит выделить обеспечение комфортного температурного режима (температура на поверхности Марса колеблется в пределах от –140 до –60 °С), для чего необходимо использовать продвинутую термоизоляцию. Другая проблема, с которой людям придется столкнуться, – солнечная радиация, которую в целях соблюдения безопасности необходимо экранировать. Поэтому важной особенностью марсианских модулей будет многослойная структура их стенок, в которых каждый слой станет выполнять определенную защитную или прочностную функцию. В частности, одним из лучших решений для защиты помещений от космического воздействия являются полиамидные пленки со специальным покрытием для экранирования опасных излучений.
Скорее всего, при строительстве обитаемых баз на Марсе будут применяться и твердые композиты на полимерной основе, которые перейдут в эту сферу из ракетостроения и космического приборостроения (современные спутники состоят из композитов на 60–70%) благодаря их высокой прочности при низкой массе.
Среди проектов, которые попали в число финалистов конкурса NASA, мне больше всего понравился вариант компании Zopherus: она предложила создать посадочный модуль, оборудованный 3D-принтером. Предполагается, что он в автоматическом режиме (с помощью роботов) будет добывать марсианскую породу и впоследствии использовать ее для печати всех необходимых сооружений.
Думаю, что современная робототехника уже достаточно близко подошла к тому, чтобы воплощать подобные решения в жизнь. Однако, помимо роботов и 3D-принтеров, для построения марсианской базы понадобится новое поколение сверхтяжелых ракетоносителей, на разработку которых может уйти несколько десятков лет при условии высокого интереса к космической технике.
Яков Утин, Александр Буланов